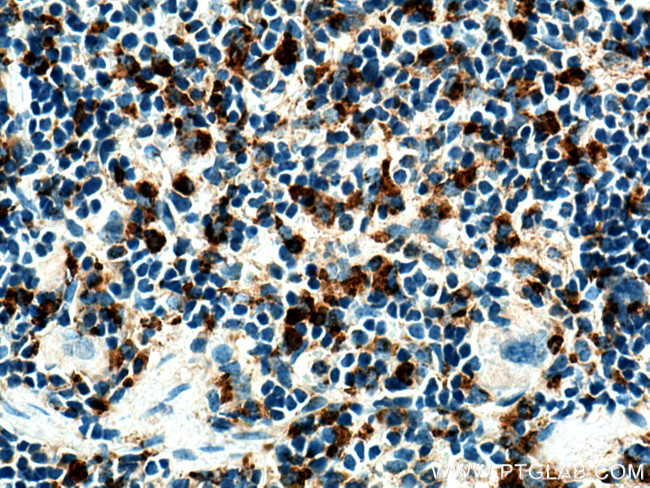
Cd68 Antibody in Immunohistochemistry (Paraffin) (IHC (P))

Search
Proteintech
Cd68 Polyclonal Antibody
{{$productOrderCtrl.translations['antibody.pdp.commerceCard.promotion.promotions']}}
{{$productOrderCtrl.translations['antibody.pdp.commerceCard.promotion.viewpromo']}}
{{$productOrderCtrl.translations['antibody.pdp.commerceCard.promotion.promocode']}}: {{promo.promoCode}} {{promo.promoTitle}} {{promo.promoDescription}}. {{$productOrderCtrl.translations['antibody.pdp.commerceCard.promotion.learnmore']}}



Please note: We are reviewing Western blot images included in the antibody testing data in our catalog, including those provided by third parties. Unless expressly labeled or annotated as “raw-unedited”, Western blot images included in the antibody testing data in our catalog may have been edited, optimized or otherwise adjusted for presentation.
产品信息
28058-1-AP
种属反应
已发表种属
宿主/亚型
分类
类型
抗原
偶联物
形式
浓度
规格
纯化类型
保存液
内含物
保存条件
运输条件
产品详细信息
Aliquoting is unnecessary for -20°C storage.
靶标信息
CD68 (Macrosialin) is a 110 kDa integral membrane glycoprotein predominantly expressed on the intracellular lysomsomes of monocytes and macrophages and to a lesser extent by dendritic cells and peripheral blood granulocytes. Also, CD68 could play a role in phagocytic activities of tissue macrophages, both in intracellular lysosomal metabolism and extracellular cell-cell and cell-pathogen interactions. CD68 is expressed by interdigitating reticulum cells in tonsil and some histiocytic lymphoma or histiocytosis, acute myeloid leukemia (AML), and granulocytic sarcoma. Elevated expression of CD68 has been demonstrated on CD34+ cells in various human malignancies, including several Acute Myeloid Leukemia studies.
仅用于科研。不用于诊断过程。未经明确授权不得转售。
生物信息学
蛋白别名: CD68; Macrosialin
基因别名: Cd68; gp110; Lamp4; Scard1
UniProt ID: (Mouse) P31996
Entrez Gene ID: (Mouse) 12514